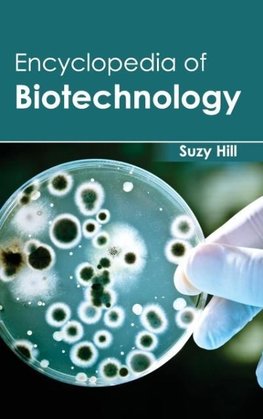
Encyclopedia of Biotechnology

-
 Anglický jazyk
Anglický jazyk
Encyclopedia of Biotechnology
Autor: Suzy Hill
A variety of information regarding the field of biotechnology is presented in this book. Biotechnology is the scientific field of researching the most resourceful techniques to get helpful products for human society by using practical micro-organisms, tissues... Viac o knihe
Na objednávku, dodanie 2-4 týždne
130.63 €
bežná cena: 137.50 €
O knihe
A variety of information regarding the field of biotechnology is presented in this book. Biotechnology is the scientific field of researching the most resourceful techniques to get helpful products for human society by using practical micro-organisms, tissues of plants or animals. It is very significant to make the precise distinction between biotechnology as a separate science of getting precious products from cells or tissues of viable organisms, and any other applications of bioprocesses that are based on using the whole living plants or animals. The book is a compilation of current advances of selected studies that are ongoing in certain biotechnological applications. This book has several well researched chapters related to the achievements made in the field of biotechnology.
- Vydavateľstvo: ML Books International - IPS
- Rok vydania: 2015
- Formát: Hardback
- Rozmer: 235 x 157 mm
- Jazyk: Anglický jazyk
- ISBN: 9781632392169












